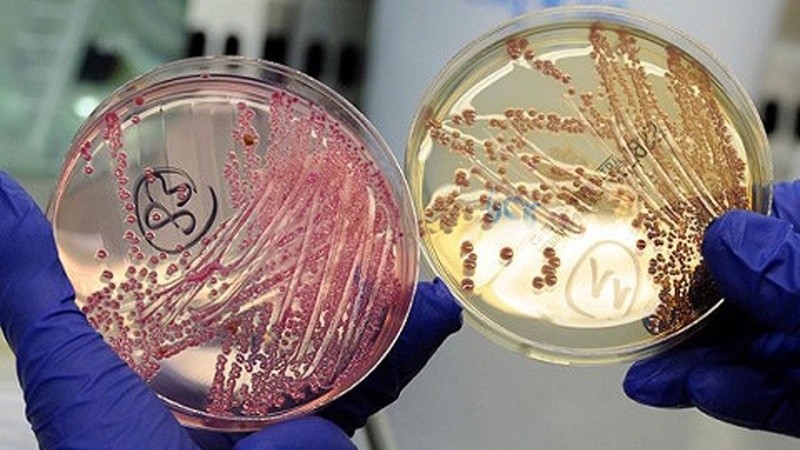

Según explicaron desde la OMS, se busca actualizar una lista que se utiliza para la investigación y el desarrollo (I+D) de vacunas, tests y tratamientos, para lo que se reunió a más de 300 científicos para que observen más de 25 familias de virus y bacterias.
"Centrarse en patógenos prioritarios y familias de virus para la investigación y el desarrollo de las contramedidas es esencial para tener una respuesta epidémica y pandémica efectiva y rápida", afirmó el director de emergencias de la OMS, Michael Ryan.
"Sin inversiones significativas en I+D antes de la pandemia de covid-19, hubiera sido imposible tener unas vacunas seguras y efectivas desarrolladas en un tiempo récord" agregó y recordó que también observarán la llamada "Enfermedad X", un patógeno desconocido que podría causar una epidemia internacional grave.
Esta lista, que se publicó por primera vez en 2017, actualmente incluye los virus del Covid-19, del Ébola y de Marburgo; la fiebre de Lassa, el Síndrome Respiratorio de Oriente Medio (MERS) y el Síndrome Respiratorio Agudo Grave (SARS), el virus Nipah, el Zika y la Enfermedad X.
Para cada patógeno identificado como prioritario, los expertos precisarán las lagunas de conocimiento y las investigaciones prioritarias, por lo que se espera que la lista sea publicada antes de abril de 2023.